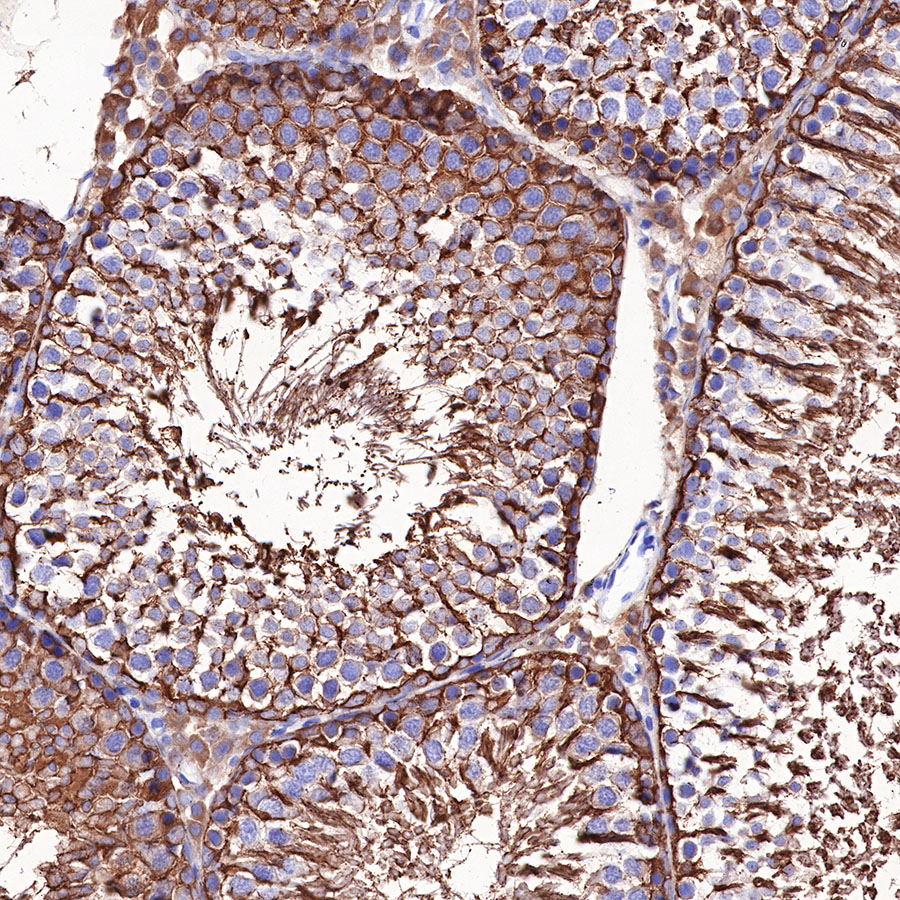

Product Details
Product Details
Product Specification
| Host | Rabbit |
| Antigen | Beta III tubulin |
| Synonyms | Tubulin beta-3 chain, Tubulin beta-4 chain, Tubulin beta-III |
| Immunogen | Synthetic Peptide |
| Location | Cytoplasm, Cytoskeleton |
| Accession | Q13509 |
| Clone Number | SDT-251-28 |
| Antibody Type | Recombinant mAb |
| Application | WB, IHC-P, ICC, ICFCM, IP |
| Reactivity | Hu, Ms, Rt |
| Purification | Protein A |
| Concentration | 0.05 mg/ml |
| Physical Appearance | Liquid |
| Storage Buffer | PBS, 40% Glycerol, 0.05% BSA, 0.03% Proclin 300 |
| Stability & Storage | 12 months from date of receipt / reconstitution, -20 °C as supplied. |
Dilution
| application | dilution | species |
| WB | 1:1000-1:5000 | |
| IHC-P | 1:200 | |
| ICFCM | 1:50 | |
| ICC | 1:50 | |
| IP | 1:25 |
Background
Beta III-tubulin is frequently overexpressed in human tumors and is associated with resistance to microtubule-targeting agents, tumor aggressiveness, and poor patient outcome [PMID: 34364992IF: 9.7 Q1 ]. In prostate cancer, βIII-tubulin expression is strongly associated with both TMPRSS2: ERG rearrangement, ERG expression and PTEN deletions, three key oncogenetic features of aggressive prostate cancer [PubMed: 24378408]. Also, colorectal cancer is more aggressive in young male patients in whom testosterone elevation and activation of TUBB3 are connected with poor outcome [PubMed: 23637935].
Picture
Picture
Western Blot



FC

Flow cytometric analysis of 4% PFA fixed 90% methanol permeabilized SH-SY5Y (Human neuroblastoma epithelial cell) cells labelling Beta III tubulin antibody at 1/50 (0.1 μg) dilution / (red) compared with a Rabbit monoclonal IgG (Black) isotype control and an unlabelled control (cells without incubation with primary antibody and secondary antibody) (Blue). Goat Anti - Rabbit IgG Alexa Fluor® 488 was used as the secondary antibody.
IP

Beta III tubulin Rabbit mAb at 1/25 dilution (0.2 µg) immunoprecipitating Beta III tubulin in 0.2 mg SH-SY5Y whole cell lysate.
Western blot was performed on the immunoprecipitate using Beta III tubulin Rabbit mAb at 1/1000 dilution.
Secondary antibody (HRP) for IP was used at 1/400 dilution.
Lane 1: SH-SY5Y whole cell lysate 5 µg (Input)
Lane 2: Beta III tubulin Rabbit mAb IP in SH-SY5Y whole cell lysate
Lane 3: Rabbit monoclonal IgG IP in SH-SY5Y whole cell lysate
Predicted MW: 50 kDa
Observed MW: 55 kDa
Immunohistochemistry

Immunocytochemistry

ICC shows positive staining in SH-SY5Y cells. Anti-Beta III tubulin antibody was used at 1/50 dilution (Green) and incubated overnight at 4°C. Goat polyclonal Antibody to Rabbit IgG - H&L (Alexa Fluor® 488) was used as secondary antibody at 1/1000 dilution. The cells were fixed with 100% ice-cold methanol and permeabilized with 0.1% PBS-Triton X-100. Nuclei were counterstained with DAPI (Blue).
